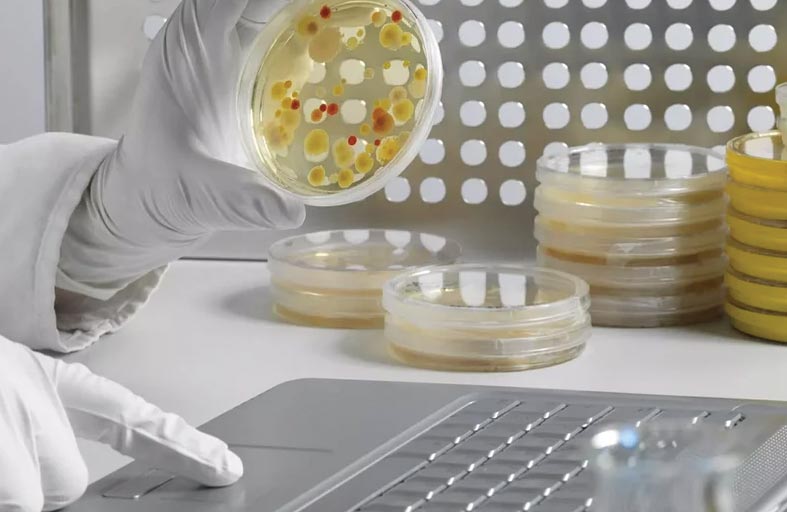

رئيس الدولة ونائباه يهنئون رئيس سيشل بمناسبة ذكرى اليوم الوطني لبلاده
دراسة: الكيبورد أكثر قذارة من مقاعد المرحاض
خلصت دراسة إلى نتائج صادمة بشأن حجم انتشار الجراثيم في لوحات المفاتيح، التي يعمل عليها كثيرون لساعات طويلة في اليوم، مشيرة إلى أن الجراثيم فيها ثلاثة أضعاف ما هو موجود في مقاعد المرحاض. وذكرت الدراسة، التي نشرت تفاصيلها صحيفة "ديلي ميل" البريطانية، أن لوحة المفاتيح تحتوي في المعدل على نفس الجراثيم الموجودة في سلة المهملات بالمطبخ، في حين أن فأرة الكمبيوتر أكثر قذارة من حصيرة الباب. وتثير النتائج قلقا، خاصة أن الموظفين يمضون ساعات طويلة على مكاتبهم يوميا، ويأكلون ويشربون عليها. وجرى أخذ عينات من 10 عناصر في المكاتب في أماكن عدة في بريطانيا، بما يشمل لوحة المفاتيح والفأرة، وجرت عملية مقارنتها بالأدوات المنزلية المعروفة بانتشار الجراثيم فيها مثل مقاعد المراحيض. وبينت النتائج أن متوسط عدد الجراثيم يبلغ 21 ألف جرثومة في كل بوصة مربعة على طاولة المكتب، بينما وصل العدد في لوحة المفاتيح إلى 3295جرثومة في كل بوصة مربعة. واحتوت الفأرة على 1676 جرثومة، في حين احتوى الهاتف بالمكتب على أكثر من 25 ألف جرثومة.